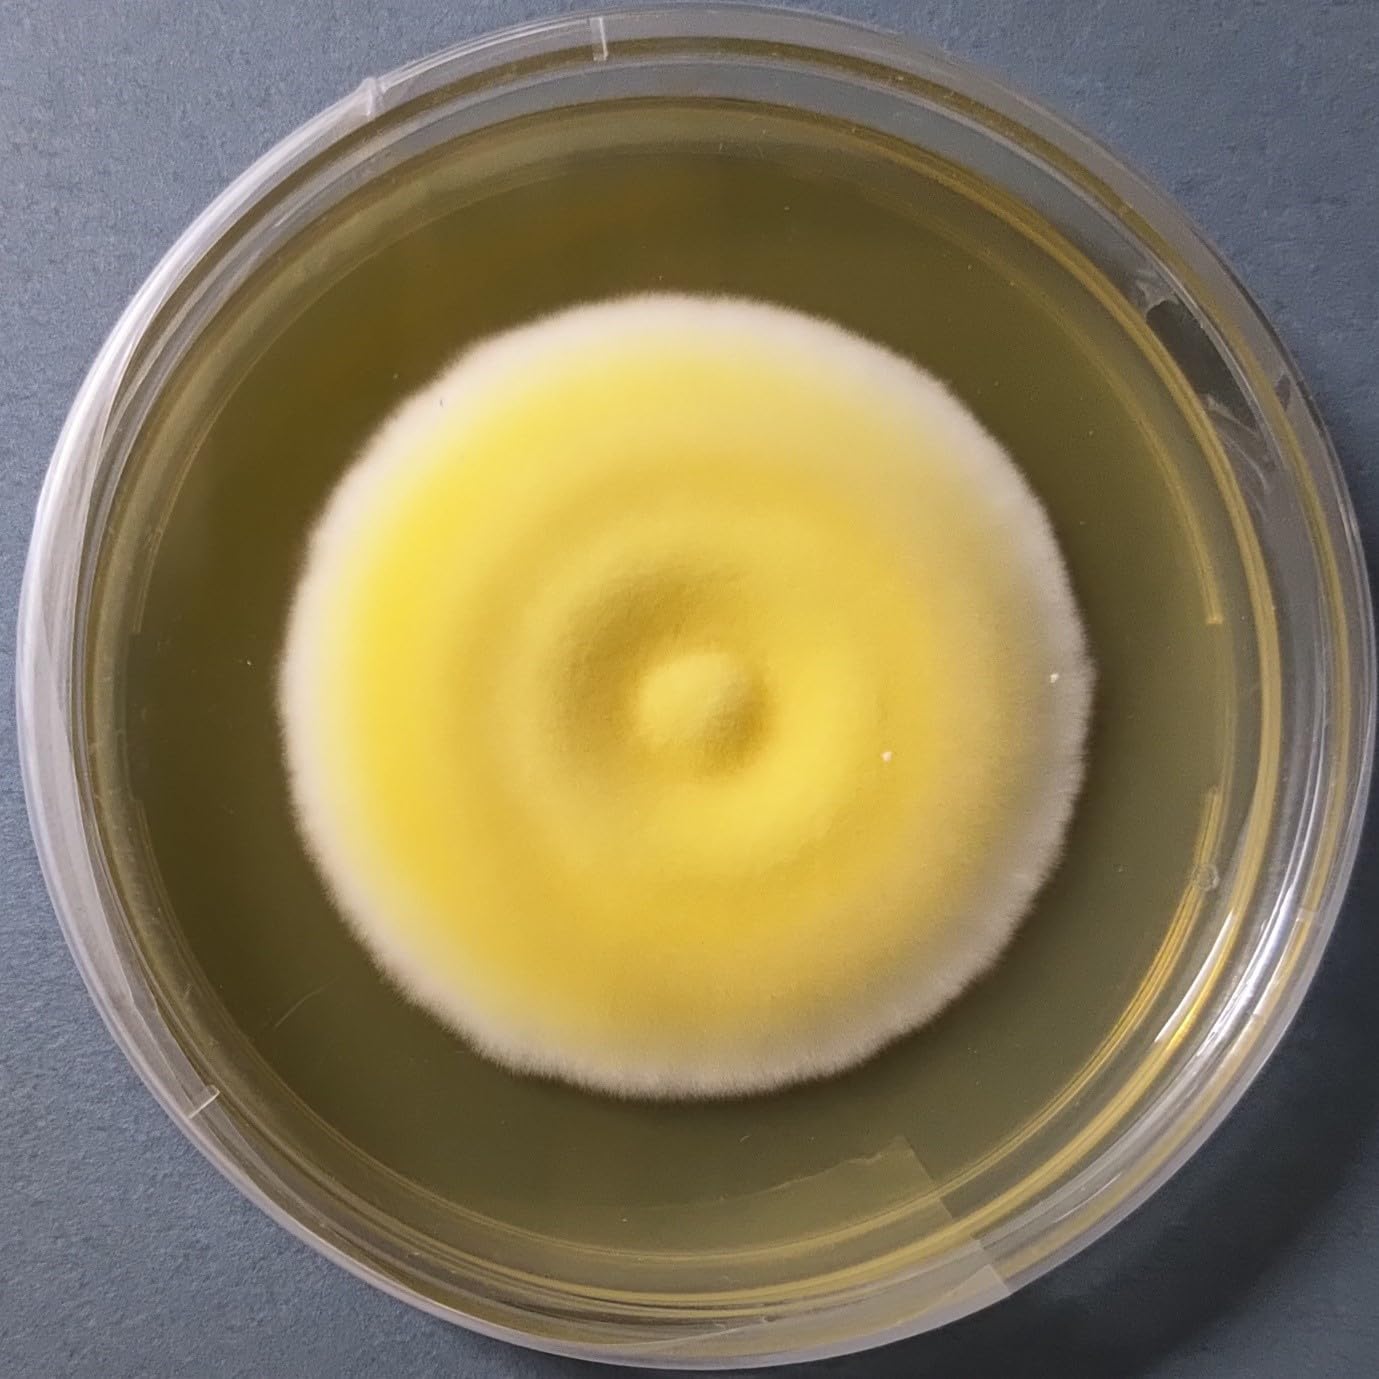
Thumbnail 2

Customer Services
Copyright © 2025 Desertcart Holdings Limited

🌟 Cultivate Success with Cordyceps!
Cordyceps militaris Culture (Liquid Culture) is a high-yield, pure liquid spawn designed for optimal cultivation. With a cordycepin content of 10.2 mg/g and a biological efficiency of 86%, this product is perfect for both novice and expert growers looking to harness the power of this remarkable fungus.
| Manufacturer | AgriPie |
| Country of Origin | India |
| Item part number | CorMil |
| ASIN | B0CFQ1JWXM |
Trustpilot
1 month ago
5 days ago
2 weeks ago
2 weeks ago